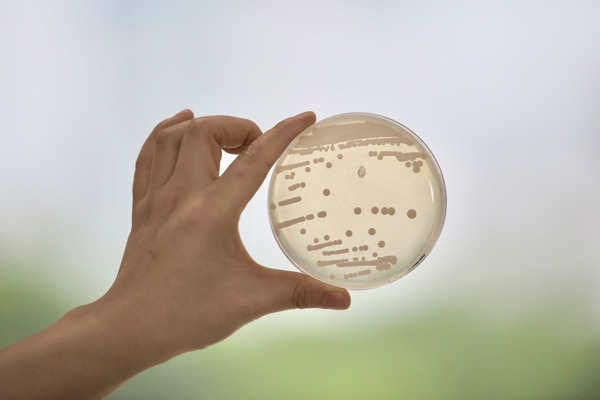
The key factor for doing better seed culture in fermentation industry

Nutriments de fermentation Blog

[Nutriments de fermentation]
Effects and application of yeast extract on the morphology of Lactobacillus acidophilus

[Nutriments de fermentation]
The application of Angel culture media for animal vaccine

[Nutriments de fermentation]
Characteristics and Functions of Angel Autolyzed Yeast Powder

[Nutriments de fermentation]
Application advantages of yeast peptone in fermentation industry
[Nutriments de fermentation]
The key factor for doing better seed culture in fermentation industry

[Nutriments de fermentation]
Customized development and application of Angel culture media

[Nutriments de fermentation]
Seed culture solution of Edible fungus

[Nutriments de fermentation]
Test of different yeast extracts for the cultivation of L. lactis

